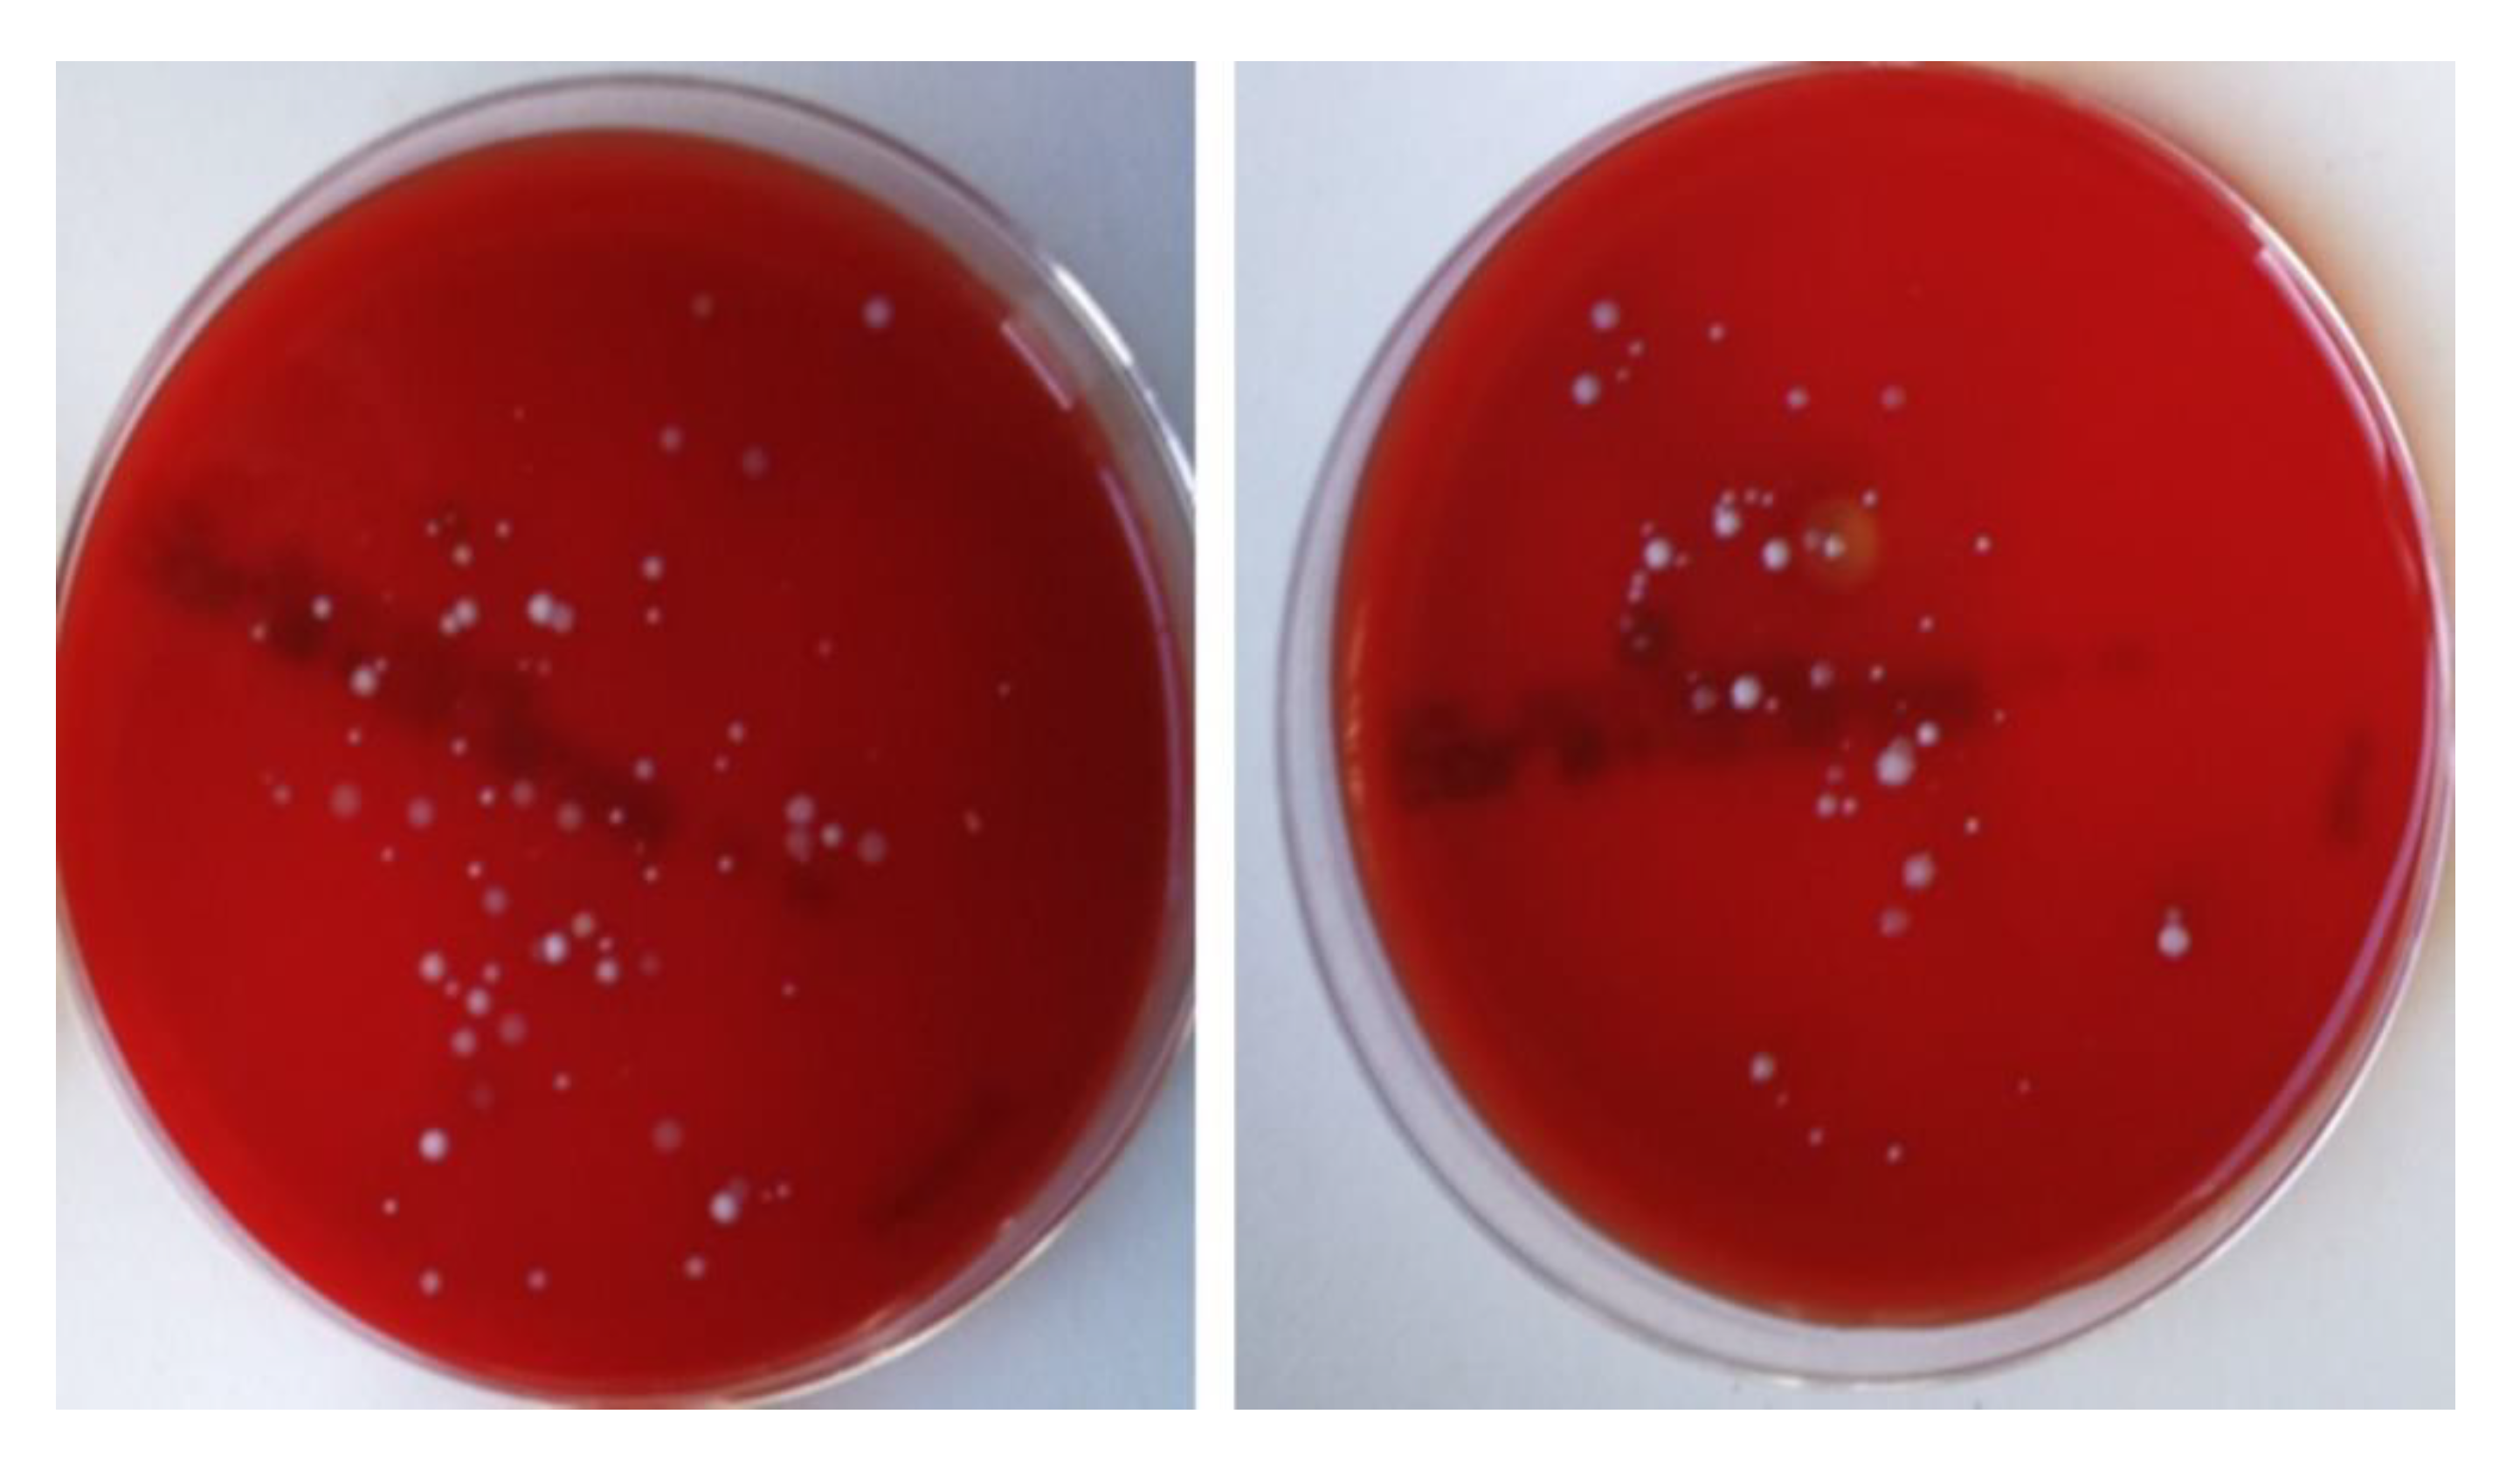
Nanomaterials 10 01568 g006

Iron Oxide Nanoparticles as an Alternative to Antibiotics Additive on Extended Boar Semen
Abstract
1. Introduction
2. Materials and Methods
2.1. Reagents and Media
2.2. Synthesis and Dispersions of Fe3O4 NPs
2.2.1. Synthesis
2.2.2. Characterization
2.3. Animals, Semen Samples Collection and Dilution
2.4. Experimental Design
2.4.1. Semen Processing with Nanoparticles (NPs)
2.4.2. Trial 1: Determination of Non-Detrimental Co-Incubation Time of Semen with NPs
2.4.3. Trial 2: Investigation of the Effect of Iron Oxide (Fe3O4) NPs on Boar Semen Quality
2.5. Sperm Kinetics/Motility
2.6. Sperm Viability
2.7. Sperm Morphology
2.8. Sperm Membrane Functionality
2.9. Sperm DNA Integrity
2.10. Microbiological Analysis
2.11. Statistical Analysis
3. Results
3.1. Nanoparticles’ Characteristics
3.2. Efficiency of the Experimental Process
3.3. Semen Variables’ Assessment
3.4. Microbiological Results
4. Discussion
Author Contributions
Funding
Acknowledgments
Conflicts of Interest
References
- Goldberg, A.M.; Argenti, L.E.; Faccin, J.E.; Linck, L.; Santi, M.; Bernardi, M.L.; Cardoso, M.R.I.; Wentz, I.; Bortolozzo, F.P. Risk factors for bacterial contamination during boar semen collection. Res. Vet. Sci. 2013, 95, 362–367. [Google Scholar] [CrossRef] [PubMed]
- Kuster, C.E.; Althouse, G.C. The impact of bacteriospermia on boar sperm storage and reproductive performance. Theriogenology 2016, 85, 21–26. [Google Scholar] [CrossRef] [PubMed]
- Maes, D.; Nauwynck, H.; Rijsselaere, T.; Mateusen, B.; Vyt, P.; de Kruif, A.; Soom, A.V. Diseases in swine transmitted by artificial insemination: An overview. Theriogenology 2008, 70, 1337–1345. [Google Scholar] [CrossRef]
- Gączarzewicz, D.; Udała, J.; Piasecka, M.; Błaszczyk, B.; Stankiewicz, T. Bacterial contamination of boar semen and its relationship to sperm quality preserved in commercial extender containing gentamicin sulfate. Pol. J. Vet. Sci. 2016, 19, 451–459. [Google Scholar] [CrossRef] [PubMed]
- Althouse, G.C.; Lu, K.G. Bacteriospermia in extended porcine semen. Theriogenology 2005, 63, 573–584. [Google Scholar] [CrossRef] [PubMed]
- Morrell, J.; Wallgren, M. Alternatives to antibiotics in semen extenders: A review. Pathogens 2014, 3, 934–946. [Google Scholar] [CrossRef]
- Schulze, M.; Dathe, M.; Waberski, D.; Müller, K. Liquid storage of boar semen: Current and future perspectives on the use of cationic antimicrobial peptides to replace antibiotics in semen extenders. Theriogenology 2016, 85, 39–46. [Google Scholar] [CrossRef]
- Speck, S.; Courtiol, A.; Junkes, C.; Dathe, M.; Müller, K.; Schulze, M. Cationic synthetic peptides: Assessment of their antimicrobial potency in liquid preserved boar semen. PLoS ONE 2014, 9, e105949. [Google Scholar] [CrossRef]
- Guzman, M.; Dille, J.; Godet, S. Synthesis and antibacterial activity of silver nanoparticles against gram-positive and gram-negative bacteria. Nanomed. Nanotechnol. Biol. Med. 2012, 8, 37–45. [Google Scholar] [CrossRef]
- Li, W.R.; Xie, X.B.; Shi, Q.S.; Zeng, H.Y.; Ouyang, Y.S.; Chen, Y.B. Antibacterial activity and mechanism of silver nanoparticles on Escherichia coli. Appl. Microbiol. Biotechnol. 2010, 85, 1115–1122. [Google Scholar] [CrossRef]
- Shahverdi, A.R.; Fakhimi, A.; Shahverdi, H.R.; Minaian, S. Synthesis and effect of silver nanoparticles on the antibacterial activity of different antibiotics against Staphylococcus aureus and Escherichia coli. Nanomed. Nanotechnol. Biol. Med. 2007, 3, 168–171. [Google Scholar] [CrossRef] [PubMed]
- Irshad, R.; Tahir, K.; Li, B.; Ahmad, A.R.; Siddiqui, A.; Nazir, S. Antibacterial activity of biochemically capped iron oxide nanoparticles: A view towards green chemistry. J. Photochem. Photobiol. B Biol. 2017, 170, 241–246. [Google Scholar] [CrossRef] [PubMed]
- Toledo, L.D.A.S.; Rosseto, H.C.; Bruschi, M.L. Iron oxide magnetic nanoparticles as antimicrobials for therapeutics. Pharmaceut. Dev. Technol. 2018, 23, 316–323. [Google Scholar] [CrossRef] [PubMed]
- Sahu, D.; Kannan, G.M.; Tailang, M.; Vijayaraghavan, R. In vitro cytotoxicity of nanoparticles: A comparison between particle size and cell type. J. Nanosci. 2016, 4023852. [Google Scholar] [CrossRef]
- Basioura, A.; Michos, I.; Ntemka, A.; Karagiannis, I.; Boscos, C.M. Effect of iron oxide and silver nanoparticles on boar semen CASA motility and kinetics. J. Hellenic Vet. Med. Soc. 2020. accepted for publication. [Google Scholar]
- Asimakidou, T.; Makridis, A.; Veintemillas-Verdaguer, S.; Morales, M.P.; Kellartzis, I.; Mitrakas, M.; Vourlias, G.; Angelakeris, M.; Simeonidis, K. Continuous production of magnetic iron oxide nanocrystals by oxidative precipitation. Chem. Eng. J. 2020, 393, 124593. [Google Scholar] [CrossRef]
- Luengo, Y.; Morales, M.P.; Gutiérrez, L.; Verdaguer, S.V. Counterion and solvent effects on the size of magnetite nanocrystals obtained by oxidative precipitation. J. Mater. Chem. 2016, 4, 9482–9488. [Google Scholar] [CrossRef]
- Powder Diffraction File; International Centre for Diffraction Data: Newtown Square, PA, USA, 2004; Joint center for powder diffraction studies.
- M100-S25 Performance Standards for Antimicrobial Susceptibility Testing; Clinical and Laboratory Standards Institute (CLSI): Wayne, PA, USA, 2015; Twenty-fifth informational supplement.
- World Health Organization (WHO). Laboratory Manual for the Examination of Human Sperm and Semen-Cervical Mucus Interaction, 5th ed.; WHO Press: Geneva, Switzerland, 2010. [Google Scholar]
- Vazquez, J.M.; Martinez, E.A.; Martinez, P.; Artiga, C.G.; Roca, J. Hypoosmotic swelling of boar spermatozoa compared to other methods for analysing the sperm membrane. Theriogenology 1997, 47, 913–922. [Google Scholar] [CrossRef]
- Tsakmakidis, I.A.; Lymberopoulos, A.G.; Khalifa, T.A.A.; Boscos, C.M.; Saratsi, A.; Alexopoulos, C. Evaluation of zearalenone and α-zearalenol toxicity on boar sperm DNA integrity. J. Appl. Toxicol. 2008, 28, 681–688. [Google Scholar] [CrossRef]
- Silva, P.F.N.; Gadella, B.M. Detection of damage in mammalian sperm cells. Theriogenology 2006, 65, 958–978. [Google Scholar] [CrossRef]
- Özgür, M.E.; Ulu, A.; Balcıoğlu, S.; Özcan, I.; Köytepe, S.; Ates, B. The toxicity assessment of iron oxide (Fe3O4) nanoparticles on physical and biochemical quality of rainbow trout spermatozoon. Toxics 2018, 6, 62. [Google Scholar] [CrossRef] [PubMed]
- Komatsu, T.; Tabata, M.; Irie, M.K.; Shimizu, T.; Suzuki, K.I.; Nihei, Y.; Takeda, K. The effects of nanoparticles on mouse testis Leydig cells in vitro. Toxicol. Vitr. 2008, 22, 1825–1831. [Google Scholar] [CrossRef] [PubMed]
- Blondin, P.; Beaulieu, M.; Fournier, V.; Morin, N.; Crawford, L.; Madan, P.; King, W.A. Analysis of bovine sexed sperm for IVF from sorting to the embryo. Theriogenology 2009, 71, 30–38. [Google Scholar] [CrossRef] [PubMed]
- Tardif, S.; Laforest, J.P.; Cormier, N.; Bailey, J.L. The importance of porcine sperm parameters on fertility in vivo. Theriogenology 1999, 52, 447–459. [Google Scholar] [CrossRef]
- Broekhuijse, M.L.; Šoštarić, E.; Feitsma, H.; Gadella, B.M. Application of computer-assisted semen analysis to explain variations in pig fertility. J. Anim. Sci. 2012, 90, 779–789. [Google Scholar] [CrossRef]
- Broekhuijse, M.L.; Feitsma, H.; Gadella, B.M. Field data analysis of boar semen quality. Reprod. Domest. Anim. 2011, 46, 59–63. [Google Scholar] [CrossRef]
- Holt, C.; Holt, W.V.; Moore, H.D.M.; Reed, H.C.B.; Curnock, R.M. Objectivily measured boar sperm motility parameters correlate with the outcomes of on-farm inseminations: Results of two fertility trials. J. Androl. 1997, 18, 312–323. [Google Scholar] [CrossRef]
- Kathiravan, P.; Kalatharan, J.; Karthikeya, G.; Rengarajan, K.; Kadirvel, G. Objective sperm motion analysis to assess dairy bull fertility using computer-aided system-a review. Reprod. Domest. Anim. 2011, 46, 165–172. [Google Scholar] [CrossRef]
- Tsakmakidis, I.A.; Lymberopoulos, A.G.; Khalifa, T.A.A. Relationship between sperm quality traits and field-fertility of porcine semen. J. Vet. Sci. 2010, 11, 151–154. [Google Scholar] [CrossRef]
- Gillan, L.; Kroetsch, T.; Chis Maxwell, W.M.; Evans, G. Assessment of in vitro sperm characteristics in relation to fertility in dairy bulls. Anim. Reprod. Sci. 2008, 103, 201–214. [Google Scholar] [CrossRef]
- Feugang, J.M.; Shengfa, F.L.; Crenshaw, M.A.; Clemente, H.; Willard, S.T.; Ryan, P.L. Lectin-functionalized magnetic iron oxide nanoparticles for reproductive improvement. JFIV Reprod. Med. Genet. 2014, 03, 1–5. [Google Scholar] [CrossRef]
- Odhiambo, J.F.; DeJarnette, J.M.; Geary, T.W.; Kennedy, C.E.; Suarez, S.S.; Sutovsky, M.; Sutovsky, P. Increased conception rates in beef cattle inseminated with nanopurified bull semen1. Biol. Reprod. 2014, 91, 1–10. [Google Scholar] [CrossRef] [PubMed]
- Brooking, J.; Davis, S.S.; Illum, L. Transport of nanoparticles across the rat nasal mucosa. J. Drug Target. 2001, 9, 267–279. [Google Scholar] [CrossRef] [PubMed]
- Wang, R.; Song, B.; Wu, J.; Zhang, Y.; Chen, A.; Shao, L. Potential adverse effects of nanoparticles on the reproductive system. Int. J. Nanomed. 2018, 13, 8487–8506. [Google Scholar] [CrossRef]
- Lamirande, E.D.; Tsai, C.; Harakat, A.; Gagnon, C. Involvement of reactive oxygen species in human sperm arcosome reaction induced by A23187, lysophosphatidylcholine, and biological fluid ultrafiltrates. J. Androl. 1998, 19, 585–594. [Google Scholar] [CrossRef]
- Yoshida, Y.; Itoh, N.; Saito, Y.; Hayakawa, M.; Niki, E. Application of water-soluble radical initiator, 2,2′-azobis-[2-(2-imidazolin-2-yl)propane] dihydrochloride, to a study of oxidative stress. Free Radic. Res. 2004, 38, 375–384. [Google Scholar] [CrossRef]
- Council Directive, European Union, 90/429/EEC. Available online: http://faolex.fao.org/docs/pdf/eur110397.pdf (accessed on 28 October 2014).
- Salamon, S.; Maxwell, W.M. Storage of ram semen. Anim. Reprod. Sci. 2000, 62, 77–111. [Google Scholar] [CrossRef]
- Ahmad, K.; Foote, R.H.; Kaproth, M. Antibiotics for bull semen frozen in milk and egg yolk extenders. J. Dairy Sci. 1987, 70, 2439–2443. [Google Scholar] [CrossRef]
- Gadea, J. Review: Semen extenders used in the artificial inseminarion of swine. Span. J. Agric. Res. 2003, 1, 17. [Google Scholar] [CrossRef]
- Lorton, S.P.; Sullivan, J.J.; Bean, B.; Kaproth, M.; Kellgren, H.; Marshall, C. A new antibiotic combination for frozen bovine semen. 2. Evaluation of seminal quality. Theriogenology 1988, 29, 593–607. [Google Scholar] [CrossRef]
- Azawi, O.I.; Ismaeel, M.A. Influence of addition of different antibiotics in semen diluent on viable bacterial count and spermatozoal viability of awassi ram semen. Vet. World 2012, 5, 75–79. [Google Scholar] [CrossRef]
- Varner, D.D.; Scanlan, C.M.; Thompson, J.A.; Brumbaugh, G.W.; Blanchard, T.L.; Carlton, C.M.; Johnson, L. Bacteriology of preserved stallion semen and antibiotics in semen extenders. Theriogenology 1998, 50, 559–573. [Google Scholar] [CrossRef]
- Oehler, C.; Janett, F.; Schmitt, S.; Malama, E.; Bollwein, H. Development of a flow cytometric assay to assess the bacterial count in boar semen. Theriogenology 2019, 133, 125–134. [Google Scholar] [CrossRef] [PubMed]
- Saqib, S.; Munis, M.F.H.; Zaman, W.; Ullah, F.; Shah, S.N.; Ayaz, A.; Farooq, M.; Bahadur, S. Synthesis, characterization and use of iron oxide nano particles for antibacterial activity. Microsc. Res. Tech. 2019, 82, 415–420. [Google Scholar] [CrossRef]
- Gabrielyan, L.; Hakobyan, L.; Hovhannisyan, A.; Trchounian, A. Effects of iron oxide (Fe3O4) nanoparticles on Escherichia coli antibiotic-resistant strains. J. Appl. Microbiol. 2019, 126, 1108–1116. [Google Scholar] [CrossRef] [PubMed]
- Margabandhu, M.; Sendhilnathan, S.; Maragathavalli, S.; Karthikeyan, V.; Annadurai, B. Synthesis characterization and antibacterial activity of iron oxide nanoparticles. Global. J. Biosci. Biotechnol. 2015, 4, 335–341. [Google Scholar]
- Wang, L.; Hu, C.; Shao, L. The antimicrobial activity of nanoparticles: Present situation and prospects for the future. Int. J. Nanomed. 2017, 12, 1227–1249. [Google Scholar] [CrossRef]
- Ramos, M.A.D.S.; Silva, P.B.D.; Spósito, L.; Toledo, L.G.D.; Bonifácio, B.V.; Rodero, C.F.; Santos, K.C.D.; Chorilli, M.; Bauab, T.M. Nanotechnology-based drug delivery systems for control of microbial biofilms: A review. Int. J. Nanomed. 2018, 13, 1179–1213. [Google Scholar] [CrossRef]
- Arakha, M.; Pal, S.; Samantarrai, D.; Panigrahi, T.K.; Mallick, B.C.; Pramanik, K.; Mallick, B.; Jha, S. Antimicrobial activity of iron oxide nanoparticle upon modulation of nanoparticle-bacteria interface. Sci. Rep. 2015, 5, 14813. [Google Scholar] [CrossRef]
- Armijo, L.M.; Wawrzyniec, S.J.; Kopciuch, M.; Brandt, Y.I.; Rivera, A.C.; Withers, N.J.; Cook, N.C.; Huber, D.L.; Monson, T.C.; Smyth, H.D.C.; et al. Antibacterial activity of iron oxide, iron nitride, and tobramycin conjugated nanoparticles against pseudomonas aeruginosa biofilms. J. Nanobiotechnol. 2020, 18, 35. [Google Scholar] [CrossRef]

| Variable | Group C | Group Fe | p Value | ||||||
|---|---|---|---|---|---|---|---|---|---|
| 0 h | 24 h | 48 h | 0 h | 24 h | 48 h | Group | Time | G*T | |
| Rapid (%) | 68.83 ± 4.68 | 57.95 ± 4.68 | 52.17 ± 4.68 | 64.57 ± 4.68 | 51.26 ± 4.68 | 50.19 ± 4.68 | 0.26 | 0.0042 | 0.88 |
| Medium (%) | 22.85 ± 2.01 | 18.60 ± 2.01 | 23.44 ± 2.01 | 22.36 ± 2.01 | 18.72 ± 2.01 | 21.60 ± 2.01 | 0.65 | 0.09 | 0.88 |
| VCL (μm/sec) | 64.65 ± 3.14 | 62.66 ± 3.14 | 55.62 ± 3.14 | 61.57 ± 3.14 | 58.14 ± 3.14 | 55.51 ± 3.14 | 0.32 | 0.06 | 0.77 |
| VSL (μm/sec) | 25.02 ± 2.52 | 28.39 ± 2.52 | 30.39 ± 2.52 | 24.04 ± 2.52 | 27.07 ± 2.52 | 29.66 ± 2.52 | 0.63 | 0.10 | 0.99 |
| VAP (μm/sec) | 47.48 ± 3.09 | 43.32 ± 3.09 | 36.72 ± 3.09 | 46.42 ± 3.09 | 41.82 ± 3.09 | 37.78 ± 3.09 | 0.84 | 0.0107 | 0.91 |
| ALH (μm) | 2.75 ± 0.16 | 2.52 ± 0.16 | 2.29 ± 0.16 | 2.56 ± 0.16 | 2.30 ± 0.16 | 2.28 ± 0.16 | 0.29 | 0.07 | 0.80 |
| BCF (Hz) | 5.49 ± 2.45 | 5.57 ± 2.45 | 5.32 ± 2.45 | 5.26 ± 2.45 | 5.52 ± 2.45 | 5.14 ± 2.45 | 0.43 | 0.45 | 0.93 |
| STR (%) | 49.07 ± 2.85 | 49.76 ± 2.85 | 53.84 ± 2.85 | 52.81 ± 2.85 | 51.12 ± 2.85 | 55.69 ± 2.85 | 0.32 | 0.26 | 0.91 |
| WOB (%) | 72.90 ± 1.77 | 75.10 ± 1.77 | 75.77 ± 1.77 | 74.39 ± 1.77 | 76.87 ± 1.77 | 76.27 ± 1.77 | 0.39 | 0.31 | 0.93 |
| Hyper (%) | 0.74 ± 0.43 | 1.08 ± 0.43 | 0.84 ± 0.43 | 0.93 ± 0.43 | 0.99 ± 0.43 | 1.31 ± 0.43 | 0.39 | 0.16 | 0.53 |
| Variable | Control | Fe | Difference (Control-Fe) | p-Value |
|---|---|---|---|---|
| Blood Agar 24 h | 558 ± 455 | 443 ± 381 | 115 ± 103 | 0.03 |
| Blood Agar 48 h | 779 ± 651 | 616 ± 515 | 164 ± 150 | 0.03 |
| Staphylococcus spp | 314 ± 411 | 251 ± 380 | 63 ± 92 | 0.06 |
| Enterococcus spp | 5.4 ± 7.6 | 4.5 ± 8.7 | 0.9 ± 7.9 | 0.72 |
| Enterobacteriaceae | 69.9 ± 106.6 | 60.1 ± 86.5 | 9.8 ± 27.5 | 0.29 |
© 2020 by the authors. Licensee MDPI, Basel, Switzerland. This article is an open access article distributed under the terms and conditions of the Creative Commons Attribution (CC BY) license (http://creativecommons.org/licenses/by/4.0/).
Share and Cite
Tsakmakidis, I.A.; Samaras, T.; Anastasiadou, S.; Basioura, A.; Ntemka, A.; Michos, I.; Simeonidis, K.; Karagiannis, I.; Tsousis, G.; Angelakeris, M.; et al. Iron Oxide Nanoparticles as an Alternative to Antibiotics Additive on Extended Boar Semen. Nanomaterials 2020, 10, 1568. https://doi.org/10.3390/nano10081568
Tsakmakidis IA, Samaras T, Anastasiadou S, Basioura A, Ntemka A, Michos I, Simeonidis K, Karagiannis I, Tsousis G, Angelakeris M, et al. Iron Oxide Nanoparticles as an Alternative to Antibiotics Additive on Extended Boar Semen. Nanomaterials. 2020; 10(8):1568. https://doi.org/10.3390/nano10081568
Chicago/Turabian StyleTsakmakidis, Ioannis A., Theodoros Samaras, Sofia Anastasiadou, Athina Basioura, Aikaterini Ntemka, Ilias Michos, Konstantinos Simeonidis, Isidoros Karagiannis, Georgios Tsousis, Mavroeidis Angelakeris, and et al. 2020. "Iron Oxide Nanoparticles as an Alternative to Antibiotics Additive on Extended Boar Semen" Nanomaterials 10, no. 8: 1568. https://doi.org/10.3390/nano10081568
APA StyleTsakmakidis, I. A., Samaras, T., Anastasiadou, S., Basioura, A., Ntemka, A., Michos, I., Simeonidis, K., Karagiannis, I., Tsousis, G., Angelakeris, M., & Boscos, C. M. (2020). Iron Oxide Nanoparticles as an Alternative to Antibiotics Additive on Extended Boar Semen. Nanomaterials, 10(8), 1568. https://doi.org/10.3390/nano10081568

